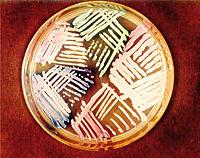

Betaagonister bør ikke anvendes til tokolyse> BMJ
Man bør ikke vælge betaagonister eller en kombination af forskellige præparater til tokolyse - eller udskydning - af en præterm fødsel. De ellers almindeligt anvendte behandlinger har en relativ høj risiko for alvorlige maternelle bivirkninger.
Det fremgår af et prospektivt kohortestudie publiceret i marts i BMJ.
Ifølge de Heus et al, University Medical Center, Utrecht, Holland, giver tokolytisk behandling bedre tid til lungemodnende behandling med steroider til barnet eller overflytning til et sygehus med neonatalafdeling.
I studiet blev der rekrutteret 1.920 konsekutive kvinder på 28 sygehuse i Holland og Belgien. Alle blev behandlet med tokolytiske præparater på grund af risiko for præterm fødsel.
I alt blev 1.327 (69%) kvinder behandlet med et enkelt præparat, 282 (14,7%) fik sekventielle behandlinger, og 311 (16,2%) fik kombinationsbehandlinger.
Den overordnede alvorlige maternelle bivirkningsrate var lav - 0,7%. Men i forhold til oxytocinantagonisten atosiban, blev en enkelt behandling med betamimetika (fx fenoterol) associeret med en 22 gange højere risiko for alvorlige bivirkninger (bl.a. svær hypotension, svær dyspnø og lungeødem).
Flerstofsbehandling var associeret med en bivirkningsrate på 1,6%.
Lone Hvidman, Gynækologisk-obstetrisk Afdeling Y, Århus Universitetshospital, kommenterer: »DSOG's obstetriske guidelines anbefaler oxytocinantagonisten atosiban som førstevalg ved behov for tokolyse med prostaglandinsyntesehæmmere som muligt alternativ ved lav gestationsalder.
Med baggrund i den aktuelle undersøgelse bør betaagonister ikke anvendes til tokolyse ved truende for tidlig fødsel på grund af risiko for svære maternelle bivirkninger. Gravide bør tilbydes den mest sikre behandling, også selvom det indebærer en øget medicinudgift, som det er tilfældet med atosiban.«
Interessekonflikter: Lone Hvidman har deltaget i kongres arrangeret af Ferring Pharmaceuticals
de Heus R, Mol BW, Erwich JHM et al. Adverse drug reactions to tocolytic treatment for preterm labour. BMJ 2009;338:b744.
Profylaktiske antibiotika er den mest effektive intervention for kemoterapipatienter
> Lancet Infect Dis
Profylaktiske antibiotika er den mest effektive behandling til at reducere infektioner og mortaliteten hos cancerpatienter i kemoterapi, konkluderer en metaanalyse publiceret i februar-nummeret af Lancet Infectious Diseases.
Agata Schlesinger, Rabin Medical Center, Petah-Tikva, Israel, og kollegaer identificerede 29 studier, som vurderede luftkontrol, profylaktiske antibiotika og isoleringsmetoder som intervention til at kontrollere infektioner hos cancerpatienter.
De fleste studier inkluderede patienter med akut leukæmi og andre hæmatologiske cancerformer. Luftkvalitetskontrol var den mest anvendte intervention, som regel kombineret med fysiske isolationsmetoder eller profylaktiske antibiotika.
De strategier, som inkluderede luftkontrol samt en anden intervention, reducerede 30-dages-mortalitetsrisikoen med 40% (risk ratio: 0,60; number needed to treat: 20). Effekten var mindre efter tre år, men number needed to treat dog stadig 20).
For at nå statistisk signifikans skulle de kombinerede strategier inkludere profylaktisk antibiotisk behandling.
Interventionerne reducerede bakteræmi, grampositive og gramnegative infektioner samt infektioner med Candida-spp.
»Vi kan konkludere, at profylaktiske antibiotika er den mest effektive behandling«, skriver forfatterne.
Jannik Helweg-Larsen, Hæmatologisk Klinik II, Rigshospitalet, kommenterer: »Analysen er primært baseret på ældre studier (før 1985) af kombineret intervention med isolation, luftfiltrering og profylaktiske antibiotika ved allogen eller autolog knoglemarvstransplantation.
Værdien af profylaktiske antibiotika som enkelt intervention er ikke undersøgt, og analysen kan ikke ekstrapoleres til cancerpatienter med lav risiko for febril neutropeni.
Studiets vigtigste fund er snarere den begrænsede evidens og behov for nye randomiserede studier af effekten af luftfiltrering/laminært airflow samt undersøgelse af hospitalisering sammenlignet med semiambulant behandling ved knoglemarvstransplantation.«
Schlesinger A, Paul M, Gafter-Gvili A et al. Infection-control interventions for cancer patients after chemotherapy. Lancet Infect Dis 2009. DOI:10.1016/S1473-3099(08)70284-6.
Fiskeolie beskytter mod katabolisk perioperativt vægttab
> Ann Surg
Enteral ernæring beriget med fiskeolie beskytter kirurgiske patienter mod katabolisk vægttab, viser en prospektiv, randomiseret og dobbeltblindet undersøgelse publiceret i marts i Annals of Surgery.
Ifølge medforfatteren John Reynolds, St. James's Hospital, Dublin, begrænser fiskeolien eikosapentaensyre-katabolismen hos patienter med avanceret cancer. »Men den perioperative virkning er ukendt«, skriver han.
I studiet rekrutteredes 53 patienter, som skulle have foretaget en øsofagusresektion. De blev randomiseret til enten konventionel enteral ernæring eller samme ernæring beriget med eikosapentaensyre (2,2 g dagligt). Patienterne fik ernæringen præoperativt i fem dage (peroralt) samt postoperativt i 21 dage (jejunostomi).
Mens patienterne i fiskeoliegruppen bevarede deres kropsvægt, tabte kontrolpatienterne i gennemsnit 1,9 kg af fedtfri masse (p = 0,03).
Der var ingen forskel på raten af alvorlige komplikationer.
Lone S. Jensen, Kirurgisk Afdeling L, Århus Universitetshospital, kommenterer: »Resultaterne fra dette studie får dog ikke store konsekvenser for de anbefalede retningslinjer til det perioperative forløb for øsofagusresecerede patienter i Danmark. Vi fokuserer på et betydeligt mere accelereret forløb med påbegyndelse af peroral indtag 1-2 dage postoperativt, hurtig mobilisering og et indlæggelsesforløb af 5-6 dages varighed.«
Ryan AM, Reynolds JV, Healy L et al. Enteral nutrition enriched with eicosapentaenoic acid (EPA) preserves lean body mass following esophageal cancer surgery. Ann Surg 2009;249:355-63.
Esomeprazol forebygger ny blødning fra peptisk ulcus uanset etnisk baggrund
> Ann Intern Med
En høj dosis intravenøs esomeprazol efter endoskopisk behandling af blødende peptisk ulcus reducerer risikoen for nye blødninger i op til 30 dage - hos både europæiske og asiatiske patienter.
Dette konkluderer en stor international undersøgelse, som publiceres i april i Annals of Internal Medicine, og som er offentliggjort på tidsskriftets hjemmeside.
»Behandlingen af blødende peptisk ulcus med protonpumpehæmmere er kontroversiel på grund af modstridende resultater fra forskellige etniske grupper«, skriver førsteforfatteren Joseph Sung, Prince of Wales Hospital, Hongkong.
I studiet blev 767 patienter med blødende peptisk ulcus samt højrisikoendoskopiske ulcuskriterier rekrutteret fra 91 centre i 16 lande, herunder Danmark.
Alle patienterne fik foretaget endoskopisk hæmostase. De blev derefter allokeret ved randomisering til enten 80 mg esomeprazol intravenøst som bolus efterfulgt af infusion med 8 mg i timen i 72 timer eller placebo. Derefter fik alle patienter 40 mg dagligt af peroral esomeprazol i 27 dage.
Færre patienter i omeprazolgruppen havde nye blødninger i løbet af de første 72 timer (5,9 vs. 10,3%), og forskellen forblev signifikant i op til 30 dage. Den gavnlige virkning var til stede både blandt patienter fra europæiske lande (5,5 vs. 10,8%) og blandt patienter fra asiatiske lande (3,7 vs. 7,4%).
Ove B. Schaffalitzky de Muckadell, Gastroenterologisk Afdeling, Odense Universitetshospital, kommenterer: »Studiet er velgennemført men temmelig ligegyldigt, idet samme informationer findes i flere tidligere Cochrane-analyser. Desuden kan der stilles spørgsmål ved den eksterne validitet, idet risikopatienter i høj grad var ekskluderet - hvilket også viser sig i den meget lave mortalitet på gennemsnitligt ca. 1,5% - den gennemsnitlige mortalitet er i Danmark ca. 11%.
Også i Cochrane- analysen var der effekt på tværs af racer, hvad angår reblødning (men ikke død) - et effektmål, der synes at være kommet til senere. Resultaterne giver herhjemme ikke anledning til ændret adfærd.«
Sung JJY, Barkun A, Kuipers EJ et al. Intravenous esomeprazole for prevention of recurrent peptic ulcer bleeding. Ann Intern Med 2009 Feb 16 (Epub ahead of print).